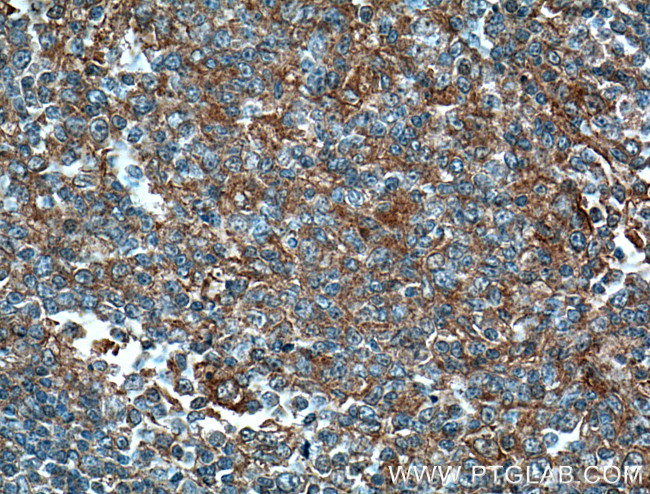
MICA Antibody in Immunohistochemistry (Paraffin) (IHC (P))
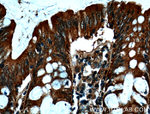
MICA Antibody in Immunohistochemistry (Paraffin) (IHC (P))

Search
Proteintech
MICA Monoclonal Antibody (1E2C8)
{{$productOrderCtrl.translations['antibody.pdp.commerceCard.promotion.promotions']}}
{{$productOrderCtrl.translations['antibody.pdp.commerceCard.promotion.viewpromo']}}
{{$productOrderCtrl.translations['antibody.pdp.commerceCard.promotion.promocode']}}: {{promo.promoCode}} {{promo.promoTitle}} {{promo.promoDescription}}. {{$productOrderCtrl.translations['antibody.pdp.commerceCard.promotion.learnmore']}}
产品信息
66384-1-IG
种属反应
宿主/亚型
分类
类型
克隆号
抗原
偶联物
形式
浓度
规格
纯化类型
保存液
内含物
保存条件
运输条件
产品详细信息
Immunogen sequence: SWDGSVQSG FLTEVHLDGQ PFLRCDRQKC RAKPQGQWAE DVLGNKTWDR ETRDLTGNGK DLRMTLAHIK DQKEGLHSLQ EIRVCEIHED NSTRSSQHFY YDGELFLSQN LETEEWTMPQ SSRAQTLAMN VRNFLKEDAM KTKTHYHAMH ADCLQELRRY LKSGVVLRRT VPPMVNVTRS EASEGNITVT CRASGFYPWN ITLSWRQDGV SLSHDTQQWG DVLPDGNGTY QTWVATRICQ GEEQRFTCYM EHSGNHSTHP VPSGKVLVLQ SHWQTFHVSA VAAAAIFVII IFYVRCCKKK TSAAEGPELV SLQVLDQHPV GTSDHRDATQ LGFQPLMSDL GSTGSTEGT (36-383 aa encoded by BC016929)
靶标信息
Major histocompatibility complex (MHC) class I proteins are ubiquitously expressed and mediate the recognition of intracellular antigens by cytotoxic T cells. A related family, termed the MHC class I chain-related (MIC) proteins are recognized by NKG2D, a receptor on NK and T cells, and promote anti-tumor activity. MICA, a member of the MIC family, is widely expressed on many tumors, and it is the MICA/NKG2D interaction that is thought to stimulate the anti-tumor reactivity by T lymphocytes. Both MICA and MICB mRNA are widely expressed in normal tissues, with MICA being present in virtually every tissue except the nervous system, suggesting that MIC protein expression may only be one component of the anti-tumor activity of the immune system.
仅用于科研。不用于诊断过程。未经明确授权不得转售。
生物信息学
蛋白别名: cell stress-regulated membrane protein; DAMA-345G11.2; HLA class I antigen; major histocompatibility complex class I chain-related protein A; MHC class I chain-related protein A; MHC class I polypeptide-related sequence A; MHC class I related chain A; MHC class I related sequence A; MIC-A; stress inducible class I homolog; unnamed protein product
基因别名: MIC-A; MICA; PERB11.1
UniProt ID: (Human) Q95IY7
Entrez Gene ID: (Human) 100507436